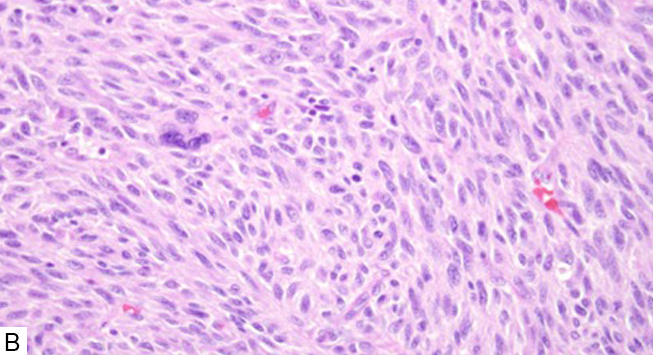

Casos clínicos
Metástasis de melanoma al tracto gastrointestinal. Reporte de tres casos
Metastasis of melanoma to the gastrointestinal tract. Report of three cases
Metástasis de melanoma al tracto gastrointestinal. Reporte de tres casos
Revista Médica del Instituto Mexicano del Seguro Social, vol. 57, núm. 1, pp. 42-47, 2019
Instituto Mexicano del Seguro Social
Recepción: 17 Noviembre 2017
Aprobación: 31 Octubre 2018
Resumen:
Introducción: el melanoma cutáneo es una de las neoplasias malignas que con mayor frecuencia metastatiza al tracto gastrointestinal. La presencia de metástasis es un factor pronóstico importante. A pesar de los avances clínicos, la supervivencia libre de enfermedad a 5 años en pacientes con melanoma cutáneo en estadio clínico IV es únicamente de 14%. Se presentan tres casos clínicos, con melanoma cutáneo metastásico a intestino.
Casos clínicos: hombre de 68 años y mujer de 55 años de edad, con metástasis en colon; hombre de 75 años de edad con metástasis a intestino delgado. Cuando presentaron síntomas grastrointestinales, fueron tratados únicamente con cirugía, con alivio de los síntomas iniciales. Dos pacientes tenían diagnóstico previo de melanoma cutáneo, con espesor de Breslow < 2 mm. Los tres pacientes fallecieron meses después de la cirugía.
Conclusión: se recomienda prestar atención especial a pacientes con historia previa de melanoma cutáneo que presenten síntomas gastrointestinales inespecíficos.
Palabras clave: Melanoma, Metástasis de la Neoplasia, Tracto Gastrointestinal.
Abstract:
Background: Cutaneous melanoma is one of the most common malignancies to metastasize to the gastrointestinal tract. Presence of tumor metastasis is an important prognostic factor. Despite clinical advances, the five-year survival rate of patients with stage IV malignant melanoma is only about 14%. We present three clinical cases with metastasis of cutaneous melanoma.
Clinical cases: Man 68 years old and woman 55 years old, with colon metastasis; and man 75 years old with metastasis to the small intestine. All of them underwent resection alone when they presented gastrointestinal symptoms and they obtained relief after it. Two patients had initial cutaneous lesions with Breslow´s thickness < 2 mm. The three patients died months after the surgery.
Conclusion: Meticulous attention to patients with prior history of cutaneous melanoma who present with subtle gastrointestinal symptoms is highly recommended.
Keywords: Melanoma, Neoplasm Metastasis, Gastrointestinal Tract.
Actualmente sabemos que el melanoma cutáneo puede afectar de manera secundaria cualquier tejido del organismo.1 En la historia natural de la enfermedad, el melanoma puede diseminarse por vía linfática y/o por vía hematógena. Las metástasis a órganos internos ocurren a través de la vía hematógena. Esto se ha asociado con mal pronóstico, y a una supervivencia media de 6 a 12 meses.2 Los patrones metastásicos de la enfermedad son impredecibles y se pueden presentar incluso décadas después del diagnóstico inicial.3 El melanoma cutáneo es la causa más común de metástasis al tracto gastrointestinal.4 El presente reporte incluye tres casos de melanoma cutáneo metastásico, en dos casos a colon y un caso a intestino delgado.
Caso 1
Hombre de 68 años de edad, con diabetes mellitus tipo 2 e hipertensión arterial sistémica, con un cuadro de un mes de evolución caracterizado por dolor abdominal difuso, vago, acompañado de náusea y constipación. En sus antecedentes heredofamiliares de importancia, se identificó un hermano diagnosticado con cáncer de colon a los 41 años de edad. Se le realizó panendoscopía, que no mostró hallazgos patológicos, sin embargo, en la colonoscopía se encontraron múltiples pólipos, sésiles y nodulares, localizados en el colon transverso y el descendente. La biopsia endoscópica mostró células de una neoplasia indiferenciada. Posteriormente, se le realizó una tomografía computada abdomino-pélvica en busca de actividad tumoral, pero no mostró hallazgos patológicos significativos. El paciente fue sometido a una hemicolectomía de colon transverso y descendente proximal.
En el análisis macroscópico de la pieza quirúrgica se observaron múltiples tumores nodulares, exofíticos, con medidas entre los 5 y 12 cm de diámetro, algunos de ellos ulcerados (figura 1A). Al corte de estos nódulos, el tejido fue blanco a gris, sólido, e involucraba todo el espesor de la pared del colon, con compromiso de la serosa y el tejido adiposo adyacente. La imagen histológica de los nódulos puso de manifiesto una proliferación de células neoplásicas predominantemente fusiformes, con formación de haces cortos que se entrecruzaban entre sí con algunas células epitelioides dispersas (figura 1B). Por la morfología y el sitio anatómico de las neoplasias, entre las opciones diagnósticas iniciales, se consideró que pudiera tratarse de un tumor estromal del tracto gastrointestinal (GIST) sincrónico, por lo que se solicitó un panel de inmunohistoquímica para complementar el diagnóstico. Las células neoplásicas expresaron positividad para CD117 en su citoplasma (figura 1C), fueron negativas para los marcadores epiteliales (pan-citoqueratinas, citoqueratina 7 y citoqueratina 20). Asimismo, se solicitó una segunda ronda de inmunohistoquímica incluyendo DOG-1, CD34, Melan A, HMB45 y proteína S-100. Las células neoplásicas fueron positivas de forma intensa y difusa para Melan A, HMB-45 y proteína S-100, y negativas para DOG-1. El diagnóstico final fue metástasis múltiple de melanoma en colon transverso y descendente proximal.

Cuatro semanas posteriores a su cirugía, el paciente acudió a consulta con oncología médica para seguimiento, durante la exploración física se le detectó un nódulo negro, de 1.5 x 0.6 cm en la piel de la cara posterior del tórax, tercio superior (figura 2). El nódulo fue resecado, el examen histológico de este espécimen mostró un melanoma nodular, con nivel de Clark IV y espesor de Breslow de 4 mm. Inicialmente se consideró tratar al paciente con quimioterapia, sin embargo, la decisión multidisciplinaria fue darle únicamente manejo sintomático. El paciente falleció por la enfermedad 3 meses después.

Caso 2
Mujer de 55 años de edad que acudió a la consulta, con historia de 3 semanas de evolución, con dolor abdominal, hematoquecia y constipación. La paciente tenía historia previa de un melanoma cutáneo de tipo diseminación superficial, en la pierna derecha, con nivel de Clark I, y espesor de Breslow de 2 mm, dicho melanoma fue resecado seis años previos al padecimiento actual. La paciente se sometió a una panendoscopía sin encontrar anormalidad. La tomografía computada abdomino-pélvica evidenció un tumor polipoide que ocupaba parcialmente la luz del colon, por lo que posteriormente se realizó una colonoscopía; se observó un tumor en colon descendente, exofítico, nodular, ulcerado, del cual se tomaron muestras para biopsias. El análisis histológico, mostró una proliferación de células neoplásicas poco diferenciadas, con formación de nidos sólidos, separadas por escaso estroma. Se realizó inmunohistoquímica, siendo las células neoplásicas positivas para proteína S100 y HMB45, lo cual aunado a la morfología, confirmó el diagnóstico de melanoma metastásico (figura 3).

A la paciente se le hizo una hemicolectomía izquierda, y en sigmoides se encontró un tumor polipoide de 6 x 5 cm. Los hallazgos microscópicos fueron idénticos a la biopsia previa. La paciente estuvo estable durante los 11 meses posteriores a la cirugía, sin embargo, murió por progresión de la enfermedad.
Caso 3
Hombre de 75 años de edad, acudió a urgencias con signos y síntomas de obstrucción intestinal. Diecinueve meses antes de su internamiento, se le había resecado una metástasis de melanoma en sistema nervioso central. También presentaba historia previa de un melanoma cutáneo de tipo diseminación superficial con nivel de Clark I, y espesor de Breslow de 1 mm, resecado en la piel del antebrazo derecho (figura 4).

Al paciente se le efectuó una laparotomía exploradora, se encontraron dos tumores polipoides en el íleon, uno de 3 cm de diámetro mayor y otro de 4 cm, separados entre sí por 6 cm (figura 5A). Al cortar el íleon se observaron dos tumores polipoides, negros, sólidos y blandos (figura 5B). La histología mostró una neoplasia compuesta por células grandes, pleomórficas, con núcleos aumentados de tamaño y nucléolos prominentes (figura 5C). Se realizaron reacciones de inmunohistoquímica, siendo las células neoplásicas positivas para proteína S-100, Melan A y HMB-45, lo que corroboró el diagnóstico de melanoma metastásico.



Después de la cirugía, el paciente recibió seis ciclos de quimioterapia. Murió 12 meses después de la cirugía, con múltiples metástasis pulmonares.
Discusión
Hasta 80% de los melanomas cutáneos que generan metástasis en el tracto gastrointestinal afectan el intestino delgado. Las lesiones se localizan predominantemente en el yeyuno distal o en el íleon. El intestino delgado es propenso a tener metástasis de melanoma cutáneo debido a su abundante flujo vascular.5 Amersi et al. encontraron el receptor 9 de quimiocina (CCR9) y su ligando CCL25, en las células del melanoma, lo cual facilita su movilidad, y favorece la presencia de metástasis en esta topografía.6
A diferencia del intestino delgado, donde las metástasis son más comunes que los tumores primarios, la mucosa colorrectal es rara vez afectada por segundas neoplasias, particularmente el colon derecho. Para determinar la incidencia de metástasis colorrectales, se realizó un estudio multi-institucional en el que se incluyeron 10 365 pacientes con tumores malignos del colon, excluyendo enfermedades sistémicas (linfoma, leucemia), el tumor metastásico más común fue el carcinoma de mama (n = 17), seguido por melanoma cutáneo (n = 7), sarcomas (n = 4), carcinoma de pulmón (n = 4), carcinoma renal (n = 2) y carcinoma de células de Merkel (n = 1).7
En una serie de metástasis de melanoma en el tracto gastrointestinal, realizada por Adair et al., las metástasis en intestino delgado superaron a las del colon, con una relación de 4:1; asimismo, en un lapso de 25 años, solo 2 de 41 casos de melanoma cutáneo metastásico al tracto gastrointestinal, se localizaron en colon.8 Se estima que más de 60% de los pacientes con melanoma cutáneo presentará metástasis al tracto gastrointestinal. En una serie de autopsias, realizada en el Instituto Roswell Park Memorial, que incluyó a 216 pacientes con melanoma cutáneo en estadios avanzados, se observó metástasis a tracto gastrointestinal en el 43.5 %.9 En una revisión de autopsias realizada en el Memorial Sloan Kettering Cancer Center, la incidencia de metástasis al tracto gastrointestinal fue: 68% hígado, 58% intestino delgado, 22% colon, 20% estómago, 12% duodeno, 5% recto, esófago 4%, y ano 1%.10
En otra serie de casos del Massachusetts General Hospital, de 115 pacientes con diagnóstico confirmado de melanoma cutáneo metastásico entre los años 1995 y 2005, los sitios más comunes de metástasis fueron el hígado (63%) y pulmón (24%).11
Únicamente entre el 1-5% de los casos de melanoma cutáneo metastásico son diagnosticados en el transcurso de la vida, debido a que son clínicamente asintomáticos en estadios tempranos.12 En los casos presentados las lesiones cutáneas fueron detectadas antes, y una de ellas después del diagnóstico de las metástasis gastrointestinales. En el estudio de Sanky et al. el lapso transcurrido entre el diagnóstico inicial de melanoma cutáneo y la detección posterior de metástasis al tracto gastrointestinal fue de 48 meses (rango de 0 a 489);13 mientras que en el estudio de Gutman fue de 38.5 meses (rango 1 a 258).14
Aproximadamente en 5% de los pacientes con melanoma cutáneo metastásico, la lesión primaria no se encuentra. Por otro lado, se ha reportado que puede ocurrir regresión de la lesión inicial, lo cual podría explicar la ausencia de un tumor primario en algunos de estos pacientes.1 En los tres pacientes de este reporte, la lesión primaria fue encontrada.
Se observa con frecuencia cierto retraso entre el inicio de los síntomas y el diagnóstico de metástasis gastrointestinales, como se ha evidenciado en esta y otras series de la literatura.1,2 En pacientes con historia previa de melanoma cutáneo, anemia aguda, sangrado de tubo digestivo, constipación y otros síntomas inespecíficos, como dolor abdominal y náusea, se debe considerar, entre los diagnósticos diferenciales, la posibilidad de melanoma metastásico al tracto gastrointestinal. Todas estas manifestaciones clínicas se presentaron en los tres pacientes descritos.
El subtipo más común de melanoma cutáneo es el de diseminación superficial, de ahí que sea también este tipo de melanoma el que con mayor frecuencia da metástasis al tracto gastrointestinal, sin embargo, es importante resaltar que cualquier subtipo de melanoma cutáneo puede metastatizar al tracto gastrointestinal.2,10,15 Patel et al. reportaron dos pacientes con metástasis en tracto gastrointestinal, con lesiones cutáneas previas con espesor de Breslow menor a 1 mm, lo cual es considerado de bajo riesgo para el desarrollo de enfermedad metastásica.9 Otros autores han reportado que hasta 56% de los pacientes sometidos a metastasectomías en tracto gastrointestinal, tenían como neoplasia primaria un melanoma cutáneo con espesor de Breslow < 2 mm.13,16 Esto coincide con dos de los casos aquí reportados, con un espesor de Breslow de 1 y 2 mm.
La tomografía computada es la modalidad más usada para investigar la causa de síntomas gastrointestinales en los pacientes, para la estadificación y medición de respuesta a tratamiento en pacientes con melanoma cutáneo, pero el ultrasonido, la resonancia magnética y la tomografía con emisión de positrones, también juegan un papel importante en el diagnóstico y seguimiento de esta neoplasia.17 La panendoscopía y la colonoscopía ofrecen, además, la posibilidad de realizar biopsias de la lesión. La cápsula endoscópica, a pesar de su poca disponibilidad, permite un examen no invasivo de la mucosa del intestino delgado, aunque presenta dificultades para localizar el sitio exacto de la lesión, y no es posible la toma de biopsia.
En el examen macroscópico, las metástasis del intestino delgado pueden presentarse como nódulos únicos o múltiples, de diferentes tamaños, y pueden presentar también un crecimiento endofítico, lo cual puede conducir a intususcepción, que puede llegar a observarse en la tomografía computada.18 Bender et al. describieron cuatro aspectos macroscópicos del melanoma metastásico al intestino delgado: cavitado, infiltrante, exofítico y polipoide.19
Las metástasis de melanoma cutáneo al colon pueden ser solitarias, múltiples o manifestarse como un engrosamiento difuso de la pared.20 En el presente estudio, los tres pacientes mostraron tumores polipoides, pero uno de ellos, además, presentó una lesión de aspecto infiltrante.
El tratamiento quirúrgico para los pacientes con enfermedad confinada al intestino delgado o al colon, ofrece a los pacientes no solo alivio de la sintomatología, sino también beneficio en la supervivencia. Aun en casos en los que la resección quirúrgica es incompleta, los pacientes tienen una mejor supervivencia comparada con aquellos pacientes con enfermedad metastásica no resecada.7Los tres pacientes reportaron alivio de la sintomatología y tuvieron una sobrevida de varios meses.
Gutman et al. estudiaron las indicaciones quirúrgicas para los pacientes con melanoma cutáneo metastásico al tracto gastrointestinal. La mitad de sus pacientes se sometieron a cirugía electiva, mientras que el 22% requirieron cirugía de emergencia por obstrucción intestinal. Reportaron que las indicaciones, tanto para la cirugía electiva como para la cirugía de urgencia, no mostraron impacto en la supervivencia posoperatoria.14
En un estudio de 124 casos de melanoma cutáneo metastásico al tracto gastrointestinal, 69 pacientes (56%) se sometieron a laparotomía exploradora, de ellos, solamente 46 (67%) tuvieron resecciones completas y 23 (33%) recibieron únicamente procedimientos paliativos.21
En pacientes con melanoma cutáneo en estadio clínico IV, la tasa de supervivencia depende de dos factores: los niveles séricos de lactato deshidrogenasa y la localización de las metástasis a distancia.1,9En casos con metástasis a pulmón, cerebro, intestino delgado y colon, la supervivencia disminuye significativamente. La supervivencia promedio en pacientes con melanoma metastásico es de menos de un año.22En el estudio actual, los tres pacientes fallecieron a los 3, 11 y 12 meses posteriores a sus cirugías.
Conclusiones
En todos los pacientes con historia previa de melanoma cutáneo, que se presenten con síntomas gastrointestinales persistentes, debe considerarse la posibilidad de metástasis de melanoma al tracto gastrointestinal.
El diagnóstico requiere un examen cuidadoso de la mucosa en búsqueda de lesiones metastásicas, con toma de biopsia y estudios de inmunohistoquímica complementarios (HMB-45, Melan A y proteína S100).
La cirugía puede ser el primer procedimiento, seguido de una terapia combinada en pacientes con melanoma cutáneo estadio clínico IV.
El pronóstico de los pacientes con melanoma metastásico es ominoso.
Referencias
1. Wick MR, Gru AA. Metastatic melanoma: Pathologic characterization, current treatment, and complications of therapy. Semin Diagn Pathol. 2016;33(4):204-18. DOI: 10.1053/j.semdp.2016.04.005
2. Shuchter LM, Green R, Fraker D. Primary and metastatic diseases in malignant melanoma of the gastrointestinal tract. Curr Opin Oncol. 2000;12(2):181-5.
3. Brehmer F, Ulrich M, Haenssle HA. Strategies for early recognition of cutaneous melanoma-present and future. Dermatol Pract Concept. 2012;2(3):6. DOI: 10.5826/dpc.0203a06
4. Deutsch GB, Kirchoff DD, Faries MB. Metastasectomy for stage IV melanoma. Surg Oncol Clin Am. 2015;24(2):279-98. DOI: 10.1016/j.soc.2014.12.006
5. Conversano A, Macina S, Indellicato R, Lacavalla D, D’Abbicco D. Gastrointestinal bleeding as presentation of small bowel metastases of malignant melanoma: Is surgery a good choice?. Int J Surg Case Rep. 2014;5(10):774-8. DOI: 10.1016/j.ijscr.2014.09.003
6. Amersi FF, Terando AM, Goto Y, Scolyer RA, Thompson JF, Tran AN, et al. Activation of CCR9/CCL25 in cutaneous melanoma mediates preferential metastasis to the small intestine. Clin Cancer Res. 2008;14(3):638-45. DOI: 10.1158/1078-0432.CCR-07-2025
7. Mourra N, Jouret-Mourin A, Lazure T, Audard V, Albiges L, Malbois M, et al. Metastatic tumors to the colon and rectum. A multi-institutional study. Arch Pathol Lab Med. 2012;136(11):1397-401. DOI: 10.5858/arpa.2011-0432-OA
8. Adair C, Ro JY, Sahin AA, El-Naggar AK, Ordónẽz NG, Ayala AG. Malignant melanoma metastatic to gastrointestinal tract: a clinicopathologic study. Int J Surg Pathol. 1994;2(1):3-9.
9. Patel JK, Didolkar MS, Pickren JW, Moore RH. Metastatic pattern of malignant melanoma. A study of 216 autopsy cases. Am J Surg. 1978;135(6):807-10. DOI:10.1016/0002-9610(78)90171-X
10. Das Gupta TK, Brasfield RD. Mestastatic Melanoma of the Gastrointestinal Tract. Arch Surg. 1964;88(6):969-73. DOI: 10.1001/archsurg.1964.01310240065013
11. Nagy AY, Forcione DG. Sa1805 Metastatic Patterns of Malignant Melanoma to the Gastrointestinal Tract, Liver and Pancreas: A Retrospective Case Series of 115 Patients. Gastroenterology. 2016;150(4)Supl 1:S371. DOI: 10.1016/S0016-5085(16)31305-1
12. Garbe C, Peris K, Hauschild A, Saiag P, Middleton M, Bastholt L, et al. Diagnosis and treatment of melanoma. European consensus-based interdisciplinary guideline-Updated 2016. Eur J Cancer. 2016;63:201-17. DOI: 10.1016/j.ejca.2016.05.005
13. Sanki A, Scolyer RA, Thompson JF. Surgery for melanoma metastases of the gastrointestinal tract: indications and results. Eur J Surg Oncol. 2009;35(3):313-9. DOI: 10.1016/j.ejso.2008.04.011
14. Gutman H, Hess KR, Kokotsakis JA, Ross MI, Guinee VF, Balch CM. Surgery for abdominal metastases of cutaneous melanoma. World J Surg. 2001;25(6):750-8. DOI: 10.1007/s00268-001-0027-2
15. Berger AC, Buell JF, Venzon D, Baker AR, Libutti SK. Management of symptomatic malignant melanoma of the gastrointestinal tract. Ann Surg Oncol. 1999;6(2):155-60.
16. Agrawal S, Yao TJ, Coit DG. Surgery for melanoma metastatic to the gastrointestinal tract. Ann Surg Oncol. 1999;6(4):336-44.
17. Patnana M, Bronstein Y, Szklaruk J, Bedi DG, Hwu WJ, Gershenwald JE, et al. Multimethod imaging, staging, and spectrum of manifestations of metastatic melanoma. Clin Radiol. 2011;66(3):224-36. DOI: 10.1016/j.crad.2010.10.014
18. Bastawrous S, McKeown E, Bastawrous A. Adult ileocolic intussusception presenting as small bowel metastatic melanoma. Radiol Case Rep. 2015;10(4):46-8. DOI: 10.1016/j.radcr.2015.08.007
19. Bender GN, Maglinte DD, McLarney JH, Rex D, Kelvin FM. Malignant melanoma: patterns of metastasis to the small bowel, reliability of imaging studies, and clinical relevance. Am J Gastroenterol. 2001;96(8):2392-400.
20. Tessier DJ, McConnell EJ, Young-Fadok T, Wolff BG. Melanoma metastatic to the colon: case series and review of the literature with outcome analysis. Dis Colon Rectum. 2003;46(4):441-7.
21. Ollila DW, Essner LA, Waneck LA, Morton DL. Surgical resection for melanoma metastatic to the gastrointestinal tract. Arch Surg. 1996;131(9):975-80.
22. Chodurek E, Orchel A, Orchel J, Kurkiewicz S, Gawlik N, Dzierzewicz Z, et al. Evaluation of melanogenesis in A-375 cells in the presence of DMSO and analysis of pyrolitic profile of isolated melanin. The Scientific World Journal. 2012:854096. DOI: 10.1100/2012/854096
Información adicional
Declaración de conflicto de interés: los autores han completado y enviado la forma traducida al español de la declaración de conflictos potenciales de interés del Comité Internacional de Editores de Revistas Médicas, y no fue reportado alguno que tuviera relación con este artículo.
Cómo citar este artículo: Alvarado-Cabrero I, Estévez-Castro R, Valencia-Cedillo R. Metástasis de melanoma al tracto gastrointestinal. Reporte de tres casos. Rev Med Inst Mex Seguro Soc. 2019;57(1): 42-7.
PubMed: https://www.ncbi.nlm.nih.gov/pubmed/?term=%2031071254
Enlace alternativo
http://revistamedica.imss.gob.mx/editorial/index.php/revista_medica/article/view/2224/3589 (pdf)
http://revistamedica.imss.gob.mx/editorial/index.php/revista_medica/article/view/2224/3599 (html)